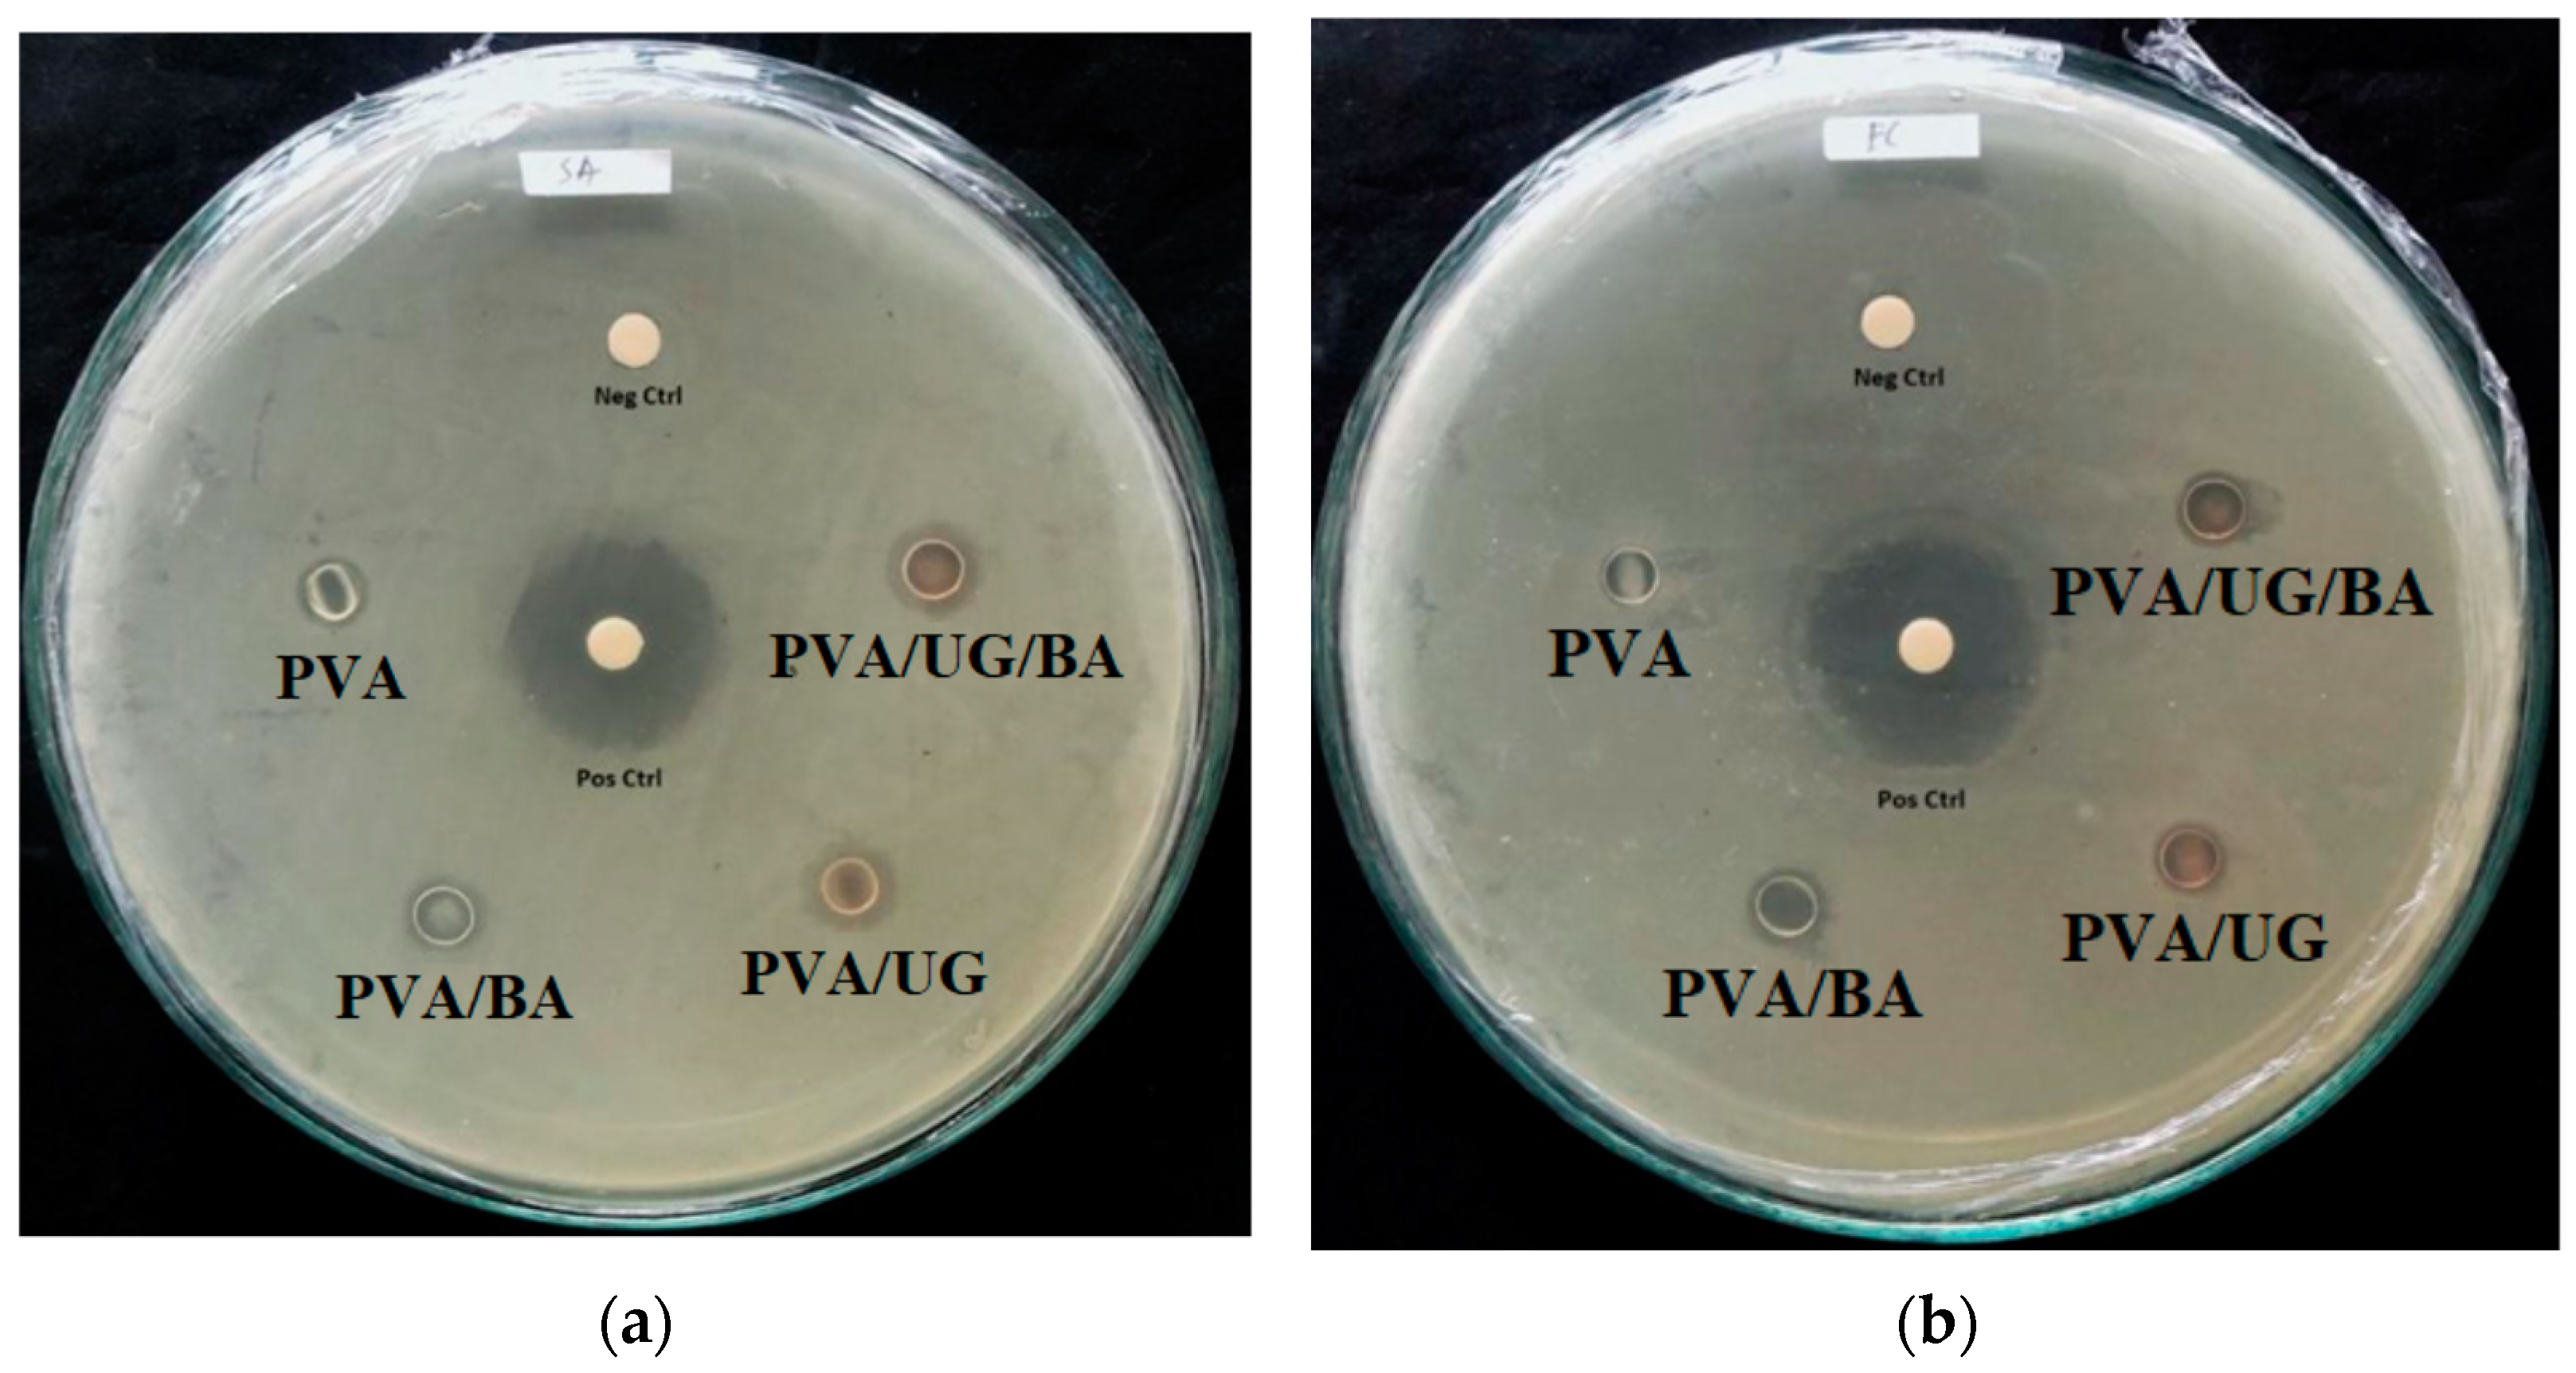
Jcs 06 00337 g008

The Enhanced Moisture Absorption and Tensile Strength of PVA/Uncaria gambir Extract by Boric Acid as a Highly Moisture-Resistant, Anti-UV, and Strong Film for Food Packaging Applications
Abstract
1. Introduction
2. Materials and Methods
2.1. Materials
2.2. Sample Preparation
2.3. FESEM Morphology
2.4. Film Transparency
2.5. Tensile Properties
2.6. FTIR
2.7. X-ray Diffraction
2.8. Thermogravimetry Analysis (TGA) and Derivative (DTG)
2.9. Moisture Absorption
2.10. Antimicrobial Activity
2.11. Statistical Analysis
3. Results and Discussions
3.1. UV and Visible Light Transparency
3.2. Cross-Section FESEM Images
3.3. FTIR Spectrum
3.4. X-ray Diffraction
| Film Samples | Transmittance (%) at 400 nm | 2 Theta (Degree) | Crystallinity (%) of (101) Plane | d-Spacing [Å] of (101) Plane | Tmax (°C) at Second Weight Loss |
|---|---|---|---|---|---|
| PVA | 70.4 | 20.17 | 27.7 | 4.398 | 312 |
| PVA/BA | 72.6 | 20.05 | 25.9 | 4.425 | 355 |
| PVA/UG | 1.3 | 20.14 | 24.5 | 4.406 | 358 |
| PVA/UG/BA | 2.0 | 20.06 | 23.9 | 4.423 | 368 |
3.5. Thermal Resistance

3.6. Tensile Properties
3.7. Moisture Absorption
3.8. Antimicrobial Properties
4. Conclusions
Author Contributions
Funding
Institutional Review Board Statement
Informed Consent Statement
Data Availability Statement
Acknowledgments
Conflicts of Interest
References
- Rahmadiawan, D.; Aslfattahi, N.; Nasruddin, N.; Saidur, R.; Arifutzzaman, A.; Mohammed, H.A. MXene Based Palm Oil Methyl Ester as an Effective Heat Transfer Fluid. J. Nano Res. 2021, 68, 17–34. [Google Scholar] [CrossRef]
- Cao, X.; Huang, J.; He, Y.; Hu, C.; Zhang, Q.; Yin, X.; Wu, W.; Li, R.K.Y. Biodegradable and renewable UV-shielding polylactide composites containing hierarchical structured POSS functionalized lignin. Int. J. Biol. Macromol. 2021, 188, 323–332. [Google Scholar] [CrossRef] [PubMed]
- Wu, W.; Liu, T.; Deng, X.; Sun, Q.; Cao, X.; Feng, Y.; Wang, B.; Roy, V.A.L.; Li, R.K.Y. Ecofriendly UV-protective films based on poly(propylene carbonate) biocomposites filled with TiO2 decorated lignin. Int. J. Biol. Macromol. 2019, 126, 1030–1036. [Google Scholar] [CrossRef] [PubMed]
- Rahmadiawan, D.; Abral, H.; Yesa, W.H.; Handayani, D.; Sandrawati, N.; Sugiarti, E.; Muslimin, A.N.; Sapuan, S.M.; Ilyas, R.A. White Ginger Nanocellulose as Effective Reinforcement and Antimicrobial Polyvinyl Alcohol/ZnO Hybrid Biocomposite Films Additive for Food Packaging Applications. J. Compos. Sci. 2022, 6, 316. [Google Scholar] [CrossRef]
- Atta, O.M.; Manan, S.; Shahzad, A.; Ul-Islam, M.; Ullah, M.W.; Yang, G. Biobased materials for active food packaging: A review. Food Hydrocoll. 2022, 125, 107419. [Google Scholar] [CrossRef]
- Haghighi, H.; Gullo, M.; La China, S.; Pfeifer, F.; Siesler, H.W.; Licciardello, F.; Pulvirenti, A. Characterization of bio-nanocomposite films based on gelatin/polyvinyl alcohol blend reinforced with bacterial cellulose nanowhiskers for food packaging applications. Food Hydrocoll. 2021, 113, 106454. [Google Scholar] [CrossRef]
- Abral, H.; Atmajaya, A.; Mahardika, M.; Hafizulhaq, F.; Kadriadi; Handayani, D.; Sapuan, S.M.; Ilyas, R.A. Effect of ultrasonication duration of polyvinyl alcohol (PVA) gel on characterizations of PVA film. J. Mater. Res. Technol. 2020, 9, 2477–2486. [Google Scholar] [CrossRef]
- Heiba, Z.K.; Bakr Mohamed, M.; Ahmed, S.I. Exploring the physical properties of PVA/PEG polymeric material upon doping with nano gadolinium oxide: Exploring the physical properties of PVA/PEG polymeric material. Alex. Eng. J. 2022, 61, 3375–3383. [Google Scholar] [CrossRef]
- Gadhave, R.V.; Vineeth, S.K.; Mahanwar, P.A.; Gadekar, P.T. Effect of addition of boric acid on thermo-mechanical properties of microcrystalline cellulose/polyvinyl alcohol blend and applicability as wood adhesive. J. Adhes. Sci. Technol. 2021, 35, 1072–1086. [Google Scholar] [CrossRef]
- Alshahrani, A.A.; AlQahtani, M.; Almushaikeh, A.M.; Hassan, H.M.A.; Alzaid, M.; Alrashidi, A.N.; Alsohaimi, I.H. Synthesis, characterization, and heavy-ion rejection rate efficiency of PVA/MWCNTs and Triton X-100/MWCNTs Buckypaper membranes. J. Mater. Res. Technol. 2022, 18, 2310–2319. [Google Scholar] [CrossRef]
- Alrebdi, T.A.; Ahmed, H.A.; Alrefaee, S.H.; Adel, R.; Toghan, A.; Mostafa, A.M.; Alkallas, F.H.; Rezk, R.A. Enhanced adsorption removal of phosphate from water by Ag-doped PVA-NiO nanocomposite prepared by pulsed laser ablation method. J. Mater. Res. Technol. 2022, 20, 4356–4364. [Google Scholar] [CrossRef]
- Kalantari, K.; Mostafavi, E.; Saleh, B.; Soltantabar, P.; Webster, T.J. Chitosan/PVA hydrogels incorporated with green synthesized cerium oxide nanoparticles for wound healing applications. Eur. Polym. J. 2020, 134, 109853. [Google Scholar] [CrossRef]
- Zhang, H.; Wu, K.; Jiao, E.; Chen, B.; Shi, J.; Lu, M. Greatly improved thermal conductivity and electrical insulation for PVA composites via introducing functional carbon nitride nanosheets. Eur. Polym. J. 2021, 159, 110718. [Google Scholar] [CrossRef]
- Lei, Y.; Mao, L.; Yao, J.; Zhu, H. Improved mechanical, antibacterial and UV barrier properties of catechol-functionalized chitosan/polyvinyl alcohol biodegradable composites for active food packaging. Carbohydr. Polym. 2021, 264, 117997. [Google Scholar] [CrossRef] [PubMed]
- Abral, H.; Kadriadi; Mahardika, M.; Handayani, D.; Sugiarti, E.; Muslimin, A.N. Characterization of disintegrated bacterial cellulose nanofibers/PVA bionanocomposites prepared via ultrasonication. Int. J. Biol. Macromol. 2019, 135, 591–599. [Google Scholar] [CrossRef] [PubMed]
- Yihun, F.A.; Ifuku, S.; Saimoto, H.; Yihun, D.A. Thermo-mechanically improved polyvinyl alcohol composite films using maleated chitin nanofibers as nano-reinforcement. Cellulose 2021, 28, 2965–2980. [Google Scholar] [CrossRef]
- Menazea, A.A.; Ismail, A.M.; Awwad, N.S.; Ibrahium, H.A. Physical characterization and antibacterial activity of PVA/Chitosan matrix doped by selenium nanoparticles prepared via one-pot laser ablation route. J. Mater. Res. Technol. 2020, 9, 9598–9606. [Google Scholar] [CrossRef]
- Abral, H.; Ariksa, J.; Mahardika, M.; Handayani, D.; Aminah, I.; Sandrawati, N.; Sapuan, S.M.; Ilyas, R.A. Highly transparent and antimicrobial PVA based bionanocomposites reinforced by ginger nanofiber. Polym. Test. 2019, 81, 106186. [Google Scholar] [CrossRef]
- Mahardika, M.; Abral, H.; Kasim, A.; Arief, S.; Hafizulhaq, F.; Asrofi, M. Properties of cellulose nanofiber/bengkoang starch bionanocomposites: Effect of fiber loading. LWT—Food Sci. Technol. 2019, 116, 108554. [Google Scholar] [CrossRef]
- Lim, M.; Kwon, H.; Kim, D.; Seo, J.; Han, H.; Khan, S.B. Highly-enhanced water resistant and oxygen barrier properties of cross-linked poly(vinyl alcohol) hybrid films for packaging applications. Prog. Org. Coat. 2015, 85, 68–75. [Google Scholar] [CrossRef]
- Gadhave, R.V.; Dhawale, P.V.; Gadekar, P.T. Effect of boric acid on poly vinyl alcohol- tannin blend and its application as water-based wood adhesive. Des. Monomers Polym. 2020, 23, 188–196. [Google Scholar] [CrossRef] [PubMed]
- Dhawale, P.V.; Vineeth, S.K.; Gadhave, R.V.; Fatima, M.J.; Supekar, M.V.; Thakur, V.K.; Raghavan, P. Tannin as a renewable raw material for adhesive applications: A review. Mater. Adv. 2022, 3, 3365–3388. [Google Scholar] [CrossRef]
- Wang, Y.; Li, T.; Ma, P.; Bai, H.; Xie, Y.; Chen, M.; Dong, W. Simultaneous Enhancements of UV-Shielding Properties and Photostability of Poly(vinyl alcohol) via Incorporation of Sepia Eumelanin. ACS Sustain. Chem. Eng. 2016, 4, 2252–2258. [Google Scholar] [CrossRef]
- Zhao, Z.; Mao, A.; Gao, W.; Bai, H. A facile in situ method to fabricate transparent, flexible polyvinyl alcohol/ZnO film for UV-shielding. Compos. Commun. 2018, 10, 157–162. [Google Scholar] [CrossRef]
- Posoknistakul, P.; Tangkrakul, C.; Chaosuanphae, P.; Deepentham, S.; Techasawong, W.; Phonphirunrot, N.; Bairak, S.; Sakdaronnarong, C.; Laosiripojana, N. Fabrication and characterization of lignin particles and their ultraviolet protection ability in PVA composite film. ACS Omega 2020, 5, 20976–20982. [Google Scholar] [CrossRef]
- Yang, W.; Ding, H.; Qi, G.; Li, C.; Xu, P.; Zheng, T.; Zhu, X.; Kenny, J.M.; Puglia, D.; Ma, P. Highly transparent PVA/nanolignin composite films with excellent UV shielding, antibacterial and antioxidant performance. React. Funct. Polym. 2021, 162, 104873. [Google Scholar] [CrossRef]
- Zhai, Y.; Wang, J.; Wang, H.; Song, T.; Hu, W.; Li, S. Preparation and characterization of antioxidative and UV-protective larch bark tannin/PVA composite membranes. Molecules 2018, 23, 2073. [Google Scholar] [CrossRef]
- Abral, H.; Ikhsan, M.; Rahmadiawan, D.; Handayani, D.; Sandrawati, N.; Sugiarti, E.; Novi, A. Anti-UV, antibacterial, strong, and high thermal resistant polyvinyl alcohol/Uncaria gambir extract biocomposite film. J. Mater. Res. Technol. 2022, 17, 2193–2202. [Google Scholar] [CrossRef]
- Abral, H.; Kurniawan, A.; Rahmadiawan, D.; Handayani, D.; Sugiarti, E.; Muslimin, A.N. Highly antimicrobial and strong cellulose-based biocomposite film prepared with bacterial cellulose powders, Uncaria gambir, and ultrasonication treatment. Int. J. Biol. Macromol. 2022, 208, 88–96. [Google Scholar] [CrossRef]
- Rahmadiawan, D.; Fuadi, Z.; Kurniawan, R.; Abral, H.; Ilhamsyah, F. Tribology in Industry Tribological Properties of Aqueous Carboxymethyl Cellulose/Uncaria Gambir Extract as Novel Anti-Corrosion Water-Based Lubricant. Tribol. Ind. 2022. [Google Scholar] [CrossRef]
- ASTM D1003; Standard Test Method for Haze and Luminous Transmittance of Transparent Plastics. American Society for Testing and Materials: West Conshohocken, PA, USA, 2006.
- ASTM D638-V; Standard Test Method for Tensile Properties of Thin Plastic Sheeting. American Society for Testing and Materials: West Conshohocken, PA, USA, 2012.
- Ricciardi, R.; Auriemma, F.; De Rosa, C.; Lauprêtre, F. X-ray Diffraction Analysis of Poly(vinyl alcohol) Hydrogels, Obtained by Freezing and Thawing Techniques. Macromolecules 2004, 37, 1921–1927. [Google Scholar] [CrossRef]
- Abral, H.; Ariksa, J.; Mahardika, M.; Handayani, D.; Aminah, I.; Sandrawati, N.; Sugiarti, E.; Muslimin, A.N.; Rosanti, S.D. Effect of heat treatment on thermal resistance, transparency and antimicrobial activity of sonicated ginger cellulose film. Carbohydr. Polym. 2020, 240, 116287. [Google Scholar] [CrossRef] [PubMed]
- Prodpran, T.; Benjakul, S.; Phatcharat, S. Effect of phenolic compounds on protein cross-linking and properties of film from fish myofibrillar protein. Int. J. Biol. Macromol. 2012, 51, 774–782. [Google Scholar] [CrossRef] [PubMed]
- Sadeghifar, H.; Venditti, R.; Jur, J.; Gorga, R.E.; Pawlak, J.J. Cellulose-Lignin Biodegradable and Flexible UV Protection Film. ACS Sustain. Chem. Eng. 2017, 5, 625–631. [Google Scholar] [CrossRef]
- Zayat, M.; Garcia-Parejo, P.; Levy, D. Preventing UV-light damage of light sensitive materials using a highly protective UV-absorbing coating. Chem. Soc. Rev. 2007, 36, 1270–1281. [Google Scholar] [CrossRef] [PubMed]
- Abral, H.; Fajrul, R.; Mahardika, M.; Handayani, D.; Sugiarti, E.; Muslimin, A.N.; Rosanti, S.D. Improving impact, tensile and thermal properties of thermoset unsaturated polyester via mixing with thermoset vinyl ester and methyl methacrylate. Polym. Test. 2020, 81, 106193. [Google Scholar] [CrossRef]
- Chen, J.; Li, Y.; Zhang, Y.; Zhu, Y. Preparation and characterization of graphene oxide reinforced PVA film with boric acid as crosslinker. J. Appl. Polym. Sci. 2015, 132, 42000. [Google Scholar] [CrossRef]
- Hong, X.; He, J.; Zou, L.; Wang, Y.; Li, Y.V. Preparation and characterization of high strength and high modulus PVA fiber via dry-wet spinning with cross-linking of boric acid. Appl. Polym. Sci. 2021, 138, 51394. [Google Scholar] [CrossRef]
- Miyazaki, T.; Takeda, Y.; Akane, S.; Itou, T.; Hoshiko, A.; En, K. Role of boric acid for a poly (vinyl alcohol) film as a cross-linking agent: Melting behaviors of the films with boric acid. Polymer 2010, 51, 5539–5549. [Google Scholar] [CrossRef]
- Ilyas, R.A.; Sapuan, S.M.; Ishak, M.R.; Zainudin, E.S. Sugar palm nanofibrillated cellulose (Arenga pinnata (Wurmb.) Merr): Effect of cycles on their yield, physic-chemical, morphological and thermal behavior. Int. J. Biol. Macromol. 2019, 123, 379–388. [Google Scholar] [CrossRef]
- Asrofi, M.; Abral, H.; Kasim, A.; Pratoto, A.; Mahardika, M.; Hafizulhaq, F. Characterization of the Sonicated Yam Bean Starch Bionanocomposites Reinforced By Nanocellulose Water Hyacinth Fiber (Whf): The Effect of Various Fiber Loading. J. Eng. Sci. Technol. 2018, 13, 2700–2715. [Google Scholar]
- Kaewprachu, P.; Rungraeng, N.; Osako, K.; Rawdkuen, S. Properties of fish myofibrillar protein film incorporated with catechin-Kradon extract. Food Packag. Shelf Life 2017, 13, 56–65. [Google Scholar] [CrossRef]
- Hong, K.H. Preparation and properties of polyvinyl alcohol/tannic acid composite film for topical treatment application. Fibers Polym. 2016, 17, 1963–1968. [Google Scholar] [CrossRef]
- De Menezes, B.R.C.; Ferreira, F.V.; Silva, B.C.; Simonetti, E.A.N.; Bastos, T.M.; Cividanes, L.S.; Thim, G.P. Effects of octadecylamine functionalization of carbon nanotubes on dispersion, polarity, and mechanical properties of CNT/HDPE nanocomposites. J. Mater. Sci. 2018, 53, 14311–14327. [Google Scholar] [CrossRef]
- Nandika, D.; Syamsu, K.; Arinana; Kusumawardhani, D.T.; Fitriana, Y. Bioactivities of catechin from gambir (uncaria gambir roxb.) against wood-decaying fungi. BioResources 2019, 14, 5646–5656. [Google Scholar] [CrossRef]
- Gutiérrez-del-Río, I.; Fernández, J.; Lombó, F. Plant nutraceuticals as antimicrobial agents in food preservation: Terpenoids, polyphenols and thiols. Int. J. Antimicrob. Agents 2018, 52, 309–315. [Google Scholar] [CrossRef]
- Xu, Z.; Du, P.; Meiser, P.; Claus, J. Proanthocyanidins: Oligomeric structures with unique biochemical properties and great therapeutic promise. Nat. Prod. Commun. 2012, 7, 381–388. [Google Scholar] [CrossRef]

| Samples | Diameter of Inhibition Zone Antimicrobial Activity (mm) | |||
|---|---|---|---|---|
| SA & | PA & | EC & | CA & | |
| PVA | 6.0 ± 0.3 | 7.0 ± 0.7 | 6.5 ± 0.2 | - |
| PVA/BA | 9.2 ± 0.3 | 9.4 ± 0.6 | 10.2 ± 1.3 | - |
| PVA/UG | 10.5 ± 0.1 | 9.5 ± 0.2 | 9.9 ± 0.9 | - |
| PVA/UG/BA | 10.6 ± 0.1 | 10.5 ± 0.5 | 9.1 ± 0.3 | - |
| Positive control | 22.4 | 23.1 | 23.5 | 25.2 |
Publisher’s Note: MDPI stays neutral with regard to jurisdictional claims in published maps and institutional affiliations. |
© 2022 by the authors. Licensee MDPI, Basel, Switzerland. This article is an open access article distributed under the terms and conditions of the Creative Commons Attribution (CC BY) license (https://creativecommons.org/licenses/by/4.0/).
Share and Cite
Rahmadiawan, D.; Abral, H.; Railis, R.M.; Iby, I.C.; Mahardika, M.; Handayani, D.; Natrana, K.D.; Juliadmi, D.; Akbar, F. The Enhanced Moisture Absorption and Tensile Strength of PVA/Uncaria gambir Extract by Boric Acid as a Highly Moisture-Resistant, Anti-UV, and Strong Film for Food Packaging Applications. J. Compos. Sci. 2022, 6, 337. https://doi.org/10.3390/jcs6110337
Rahmadiawan D, Abral H, Railis RM, Iby IC, Mahardika M, Handayani D, Natrana KD, Juliadmi D, Akbar F. The Enhanced Moisture Absorption and Tensile Strength of PVA/Uncaria gambir Extract by Boric Acid as a Highly Moisture-Resistant, Anti-UV, and Strong Film for Food Packaging Applications. Journal of Composites Science. 2022; 6(11):337. https://doi.org/10.3390/jcs6110337
Chicago/Turabian StyleRahmadiawan, Dieter, Hairul Abral, Razan Muhammad Railis, Ilham Chayri Iby, Melbi Mahardika, Dian Handayani, Khiky Dwi Natrana, Dian Juliadmi, and Fazhar Akbar. 2022. "The Enhanced Moisture Absorption and Tensile Strength of PVA/Uncaria gambir Extract by Boric Acid as a Highly Moisture-Resistant, Anti-UV, and Strong Film for Food Packaging Applications" Journal of Composites Science 6, no. 11: 337. https://doi.org/10.3390/jcs6110337
APA StyleRahmadiawan, D., Abral, H., Railis, R. M., Iby, I. C., Mahardika, M., Handayani, D., Natrana, K. D., Juliadmi, D., & Akbar, F. (2022). The Enhanced Moisture Absorption and Tensile Strength of PVA/Uncaria gambir Extract by Boric Acid as a Highly Moisture-Resistant, Anti-UV, and Strong Film for Food Packaging Applications. Journal of Composites Science, 6(11), 337. https://doi.org/10.3390/jcs6110337

